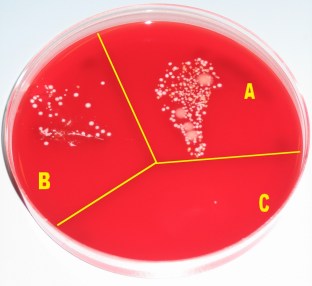
W1-Wikipedia-figure-Hand_desinfection_test_with_blood_agar_plate.jpg

Background:
It is well known that washing hands for a surprisingly long time (30 seconds!) substantially reduces microbial contamination (Figure W1).
The issue:
Unfortunately, people generally feel, psychologically speaking, that their hands are clean immediately upon rinsing them with even the slightest hint of water.
The challenge, therefore, is to encourage people to wash their hands for the recommended 30-ish seconds.
Although hand washing timers already exist, these are not sufficient—they don’t enforce the washing time.
Proposal:
To improve on the existing “hand washing timer” product, we will enhance the sink’s faucet with a “wash hands” button (Figure 2) that can control the faucet to perform pre-programmed behavior.

When the wash button is pressed, the tap performs the following actions (shown in timeline form in Figure 3):
- The tap turns on for ~5 seconds, allowing the user to get their hands wet.
- The tap turns down to a trickle for 20 seconds (allowing the user to wash their hands, but not providing enough water to wash off the soap)
- Finally, the tap turns on again, allowing the user to wash the soap off their hands.

Bonus fact:
Apparently water temperature doesn’t make a difference: “Contrary to popular belief however, scientific studies have shown that using warm water has no effect on reducing the microbial load on hands” (from https://en.wikipedia.org/wiki/Hand_washing). You can fact check that one yourself, if you want!
PROS: May reduce the spread of deadly deadly.
CONS: Could increase the rate of dry hands; this discomfort must be weighed against the severity of any to-be-prevented plagues.


You must be logged in to post a comment.